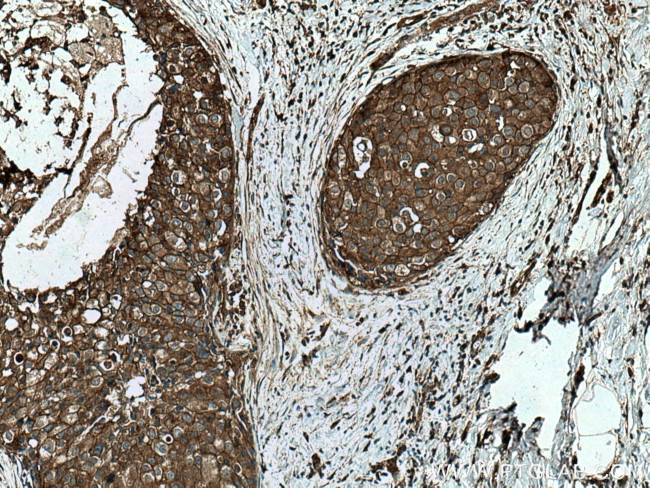
TWF1 Antibody in Immunohistochemistry (Paraffin) (IHC (P))

Search
Proteintech
TWF1 Polyclonal Antibody
{{$productOrderCtrl.translations['antibody.pdp.commerceCard.promotion.promotions']}}
{{$productOrderCtrl.translations['antibody.pdp.commerceCard.promotion.viewpromo']}}
{{$productOrderCtrl.translations['antibody.pdp.commerceCard.promotion.promocode']}}: {{promo.promoCode}} {{promo.promoTitle}} {{promo.promoDescription}}. {{$productOrderCtrl.translations['antibody.pdp.commerceCard.promotion.learnmore']}}
产品信息
11732-1-AP
种属反应
已发表种属
宿主/亚型
分类
类型
抗原
偶联物
形式
浓度
规格
纯化类型
保存液
内含物
保存条件
运输条件
产品详细信息
Immunogen sequence: ASEDVKEIF ARARNGKYRL LKISIENEQL VIGSYSQPSD SWDKDYDSFV LPLLEDKQPC YILFRLDSQN AQGYEWIFIA WSPDHSHVRQ KMLYAATRAT LKKEFGGGHI KDEVFGTVKE DVSLHGYKKY LLSQSSPAPL TAAEEELRQI KINEVQTDVG VDTKHQTLQG VAFPISREAF QALEKLNNRQ LNYVQLEIDI KNEIIILANT TNTELKDLPK RIPKDSARYH FFLYKHSHEG DYLESIVFIY SMPGYTCSIR ERMLYSSCKS RLLEIVERQL QMDVIRKIEI DNGDELTADF LYEEVHPKQH AHKQSFAKPK GPAGKRGIRR LIRGPAETEA TTD (1-343 aa encoded by BC022344)
靶标信息
This gene encodes twinfilin, an actin monomer-binding protein conserved from yeast to mammals. Studies of the mouse counterpart suggest that this protein may be an actin monomer-binding protein, and its localization to cortical G-actin-rich structures may be regulated by the small GTPase RAC1.
仅用于科研。不用于诊断过程。未经明确授权不得转售。
生物信息学
蛋白别名: A6 protein tyrosine kinase; actin monomer-binding protein; Protein A6; Protein tyrosine kinase 9; PTK9; PTK9 protein tyrosine kinase 9; twinfilin, actin-binding protein, homolog 1; Twinfilin-1; unnamed protein product
基因别名: A6; PTK9; TWF1; twinfilin
UniProt ID: (Human) Q12792, (Rat) Q5RJR2, (Mouse) Q91YR1
Entrez Gene ID: (Human) 5756, (Rat) 315265, (Mouse) 19230